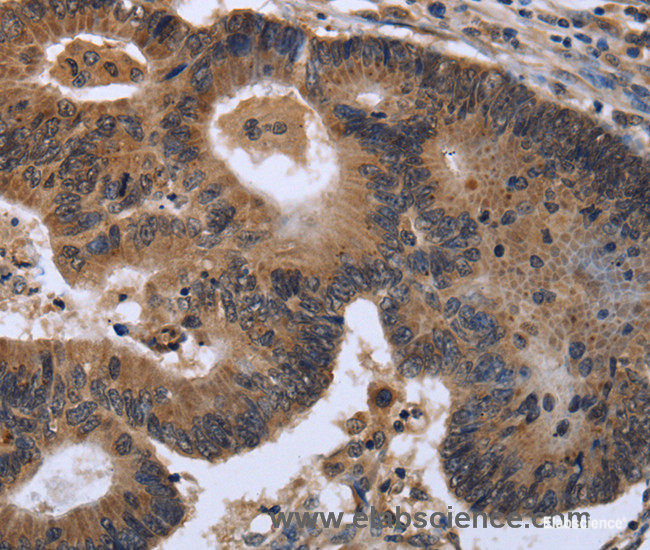
Immunohistochemistry of paraffin-embedded Human colon cancer tissue using FGF21 Polyclonal Antibody at dilution of 1:40

Elabscience
SKU:E-AB-15031
FGF21 Polyclonal Antibody
FGF21 Polyclonal Antibody
Couldn't load pickup availability
FGF21 Polyclonal Antibody
The FGF21 Polyclonal Antibody is a highly specific and sensitive tool for the detection and quantification of FGF21 protein in various biological samples. This antibody is produced by immunizing rabbits with a synthetic peptide corresponding to the C-terminal region of human FGF21 protein. The resulting polyclonal antibody has been purified using protein A affinity chromatography and validated for its specificity and sensitivity by various immunoassays.
The FGF21 Polyclonal Antibody is suitable for use in a variety of applications, including Western blotting, immunohistochemistry, and ELISA. It has been shown to detect FGF21 protein in human, mouse, and rat tissues, including liver, adipose tissue, and pancreas. This antibody has also been used to study the role of FGF21 in metabolic disorders such as obesity, diabetes, and non-alcoholic fatty liver disease.
The FGF21 Polyclonal Antibody is provided as a lyophilized powder and should be reconstituted in sterile distilled water or PBS before use. It is recommended to use this antibody at a dilution of 1:1000 for Western blotting and 1:200 for immunohistochemistry. This product is supplied with a detailed protocol for use and storage instructions.
In summary, the FGF21 Polyclonal Antibody is a reliable and effective tool for the detection and quantification of FGF21 protein in various biological samples. Its high specificity and sensitivity make it an ideal choice for researchers studying the role of FGF21 in metabolic disorders and other physiological processes.
Share